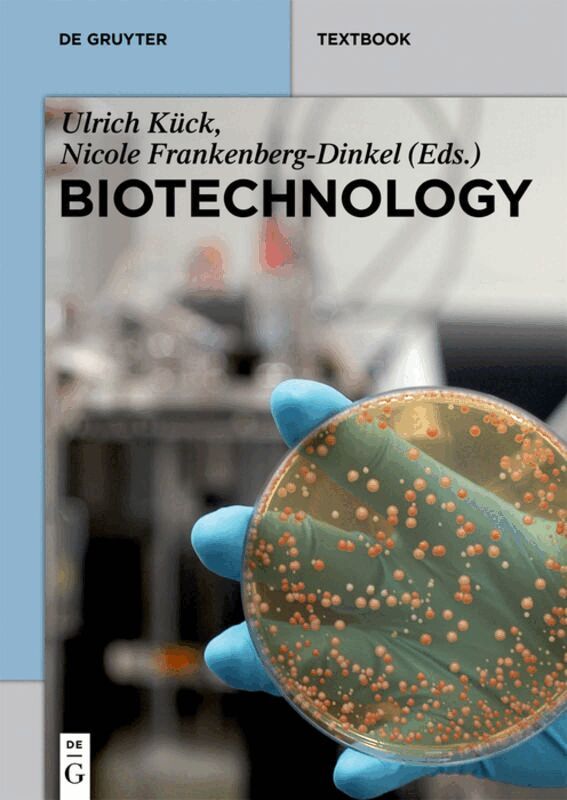

Ulrich Kück – författare
Visar alla böcker från författaren Ulrich Kück. Handla med fri frakt och snabb leverans.
5 produkter
5 produkter
Häftad, Engelska, 2015
709 kr
Skickas inom 5-8 vardagar
Biotechnology is the technical application that uses living organisms or biological systems to make products that have a profound impact on agriculture, environment, and human health.In this text book, a color-coded classification is used to present basic chapters on white, red, green and blue biotechnology. Beside traditional biotechnical processes, the book will address principles of modern biotechnology research and applications.Each chapter has a general introduction and concluding paragraph, gives key terms, will address problems, and recommends additional readings.This text book is ideally suited for advanced graduate or master students and will also be a good reference for PhD students, physicians, engineers, attorneys, or non-specialist with an interest into biotechnology.
Häftad, Engelska, 1985
1 073 kr
Skickas inom 10-15 vardagar
The possession of plasmids was for a long time recognized only in the bacteria. It is now evident that plasmids, or replicative forms of DNA structurally and experimentally comparable to bacterial plasmids, exist in eukaryotic organisms as well. Such plasmids are in fact common among fungi and higher plants. The present review is undertaken to provide a comprehensive account of the data available on plasmids found in eukaryotic organisms. This review will not consider plasmids of prokaryotic origin, even though certain bacterial plasmids, such as the tumor-inducing (Ti) plasmids of Agrobacterium tumefaciens, may be intimately associated with transformation of the eukaryotic host. This book, moreover, does not consider transformation experiments in eukaryotic hosts involving viral DNA as vectors, although indeed such vectors have been developed for use in plant and animal systems. After a general introduction, providing historical perspective on the nature and role of plasmids, a list of eukaryotic plasmids will be presented according to their origin. This is followed by a detailed discussion of known structure and function. In subsequent chapters the practical implications of eukaryotic plasmids for molecular cloning and biotechnology will be discussed. This latter part traces the development of interest'in biotechnical genetics and gives special consideration to the use of eukaryotic systems for gene cloning. The terminology biotechni cal genetics is introduced to the reader and is used in a general sense as equivalent to genetic engineering. Biotechnical genetics includes, but is not limited to, gene cloning through recombinant DNA technology.
Inbunden, Tyska, 2004
336 kr
Skickas inom 10-15 vardagar
Molekulargenetische Experimente mit mikrobiellen, pflanzlichen und tierischen ModellorganismenDie pro- und eukaryotischen Organismen, die als genetische Modellsysteme bewährt sind und verwendet werden, sind:- Escherichia coli - Bacillus subtilis - Saccharomyces cerevisiae - Neurospora crassa - Chlamydomonas reinhardtii - Arabidopsis thaliana Drosophila melanogasterDer Inhalt: - Einführung in die Biologie der Experimentalorganismen - Kreuzungsexperimente - DNA-Transformationsexperimente - Versuche zur RNA-Analytik, zur Analyse von Nukleinsäure-Protein-Interaktionen, zur PCR-Analytik, zur heterologen Genexpression und zum Einsatz von Reportergenen - BioinformatikDie optimale Mischung aus Lehrbuchtext und Experiment!
Häftad, Tyska, 2009
828 kr
Skickas inom 10-15 vardagar
Schimmelpilze – nützlich und schädlich zugleichDieses Buch gibt einen umfassenden Überblick über die guten und schlechten Seiten der Schimmelpilze. Weiterhin werden der Einsatz von Schimmelpilzen in der Biotechnologie sowie zur Herstellung von Lebensmitteln und bei der biologischen Schädlingsbekämpfung betrachtet.
Häftad, Tyska, 2014
505 kr
Skickas inom 10-15 vardagar
Diese einmalige Kombination aus Lehrbuchtext und Praktikumsanleitung bietet sowohl einen theoretischen Hintergrund als auch eine praktische Anleitung, um die Histologie von Pflanzen kennenzulernen – ideal für Bachelor-Studierende. Ohne diese Grundlagen ist ein Verständnis von komplexen pflanzlichen Entwicklungsprozessen, die durch unterschiedliche Zelltypen und Gewebe mit verschiedenen Aufgaben geprägt sind, nicht möglich.In der 3. Auflage sind einige Objekte hinzugekommen, um das Spektrum des Praktikums zu erweitern. Verschiedene Präparate, die den Niederen Pflanzen zuzurechnen sind, wurden aufgenommen, um durch einfach gebaute Organismen das Verständnis für die Funktionsweise vielzelliger Pflanzen zu entwickeln. Das Kapitel Methoden haben die Autoren um die Bedienung des Lichtmikroskops, die Objektpräparation und Färbemethoden erweitert. Das Botanische Grundpraktikum ist vom Umfang her besonders für Bachelorstudierende geeignet.